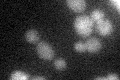
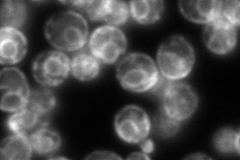
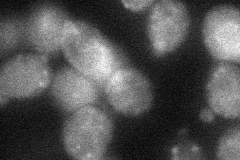
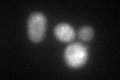
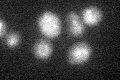

View description
Pheromone-regulated protein with 2 predicted transmembrane segments and an FF sequence, a motif involved in COPII binding; forms a complex with Prp9p in the ER; member of DUP240 gene family
Localization:
Intensity:
Fold change:
Significance:
-
C’ GFP library in SD
below threshold18.34 -
N' NOP1pr-GFP in SD

ER,punctate83.554 -
N' TEF2pr-mCherry in SD
ER,punctate206.959 -
N' NATIVEpr-GFP in SD

below threshold15.9916 -
N' TEF2pr-VC and Cyto-VN in SD
ER,punctate38.5317 -
C’ GFP library in SD+DTT
cytosol28.71.56No -
C’ GFP library in SD+H2O2

cytosol19.581.06No -
C’ GFP library in Starvation Media
cytosol30.861.68No -
C’ GFP library on the background of Pup2-DaMP

below threshold -
C’ GFP library on the background of CCT mutant

below threshold17.11640.932667No
